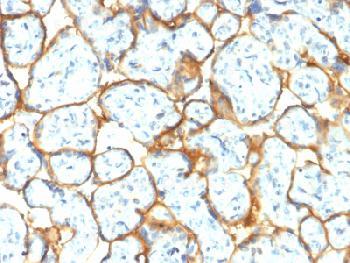

Anti-Insulin Receptor Alpha Recombinant Rabbit Monoclonal Antibody (Clone:INSR/2277R)
Fig-1: Formalin-fixed, paraffin-embedded human Placenta stained with Insulin Receptor Rabbit Recombinant Monoclonal Antibody
Roll over image to zoom in
Shipping Info:
For estimated delivery dates, please contact us at [email protected]
Format : | Purified |
Amount : | 100 µg |
Isotype : | Rabbit IgG |
Purification : | Protein A/G |
Content : | 200µg/ml of recombinant MAb purified by Protein A/G. Prepared in 10mM PBS with 0.05% BSA & 0.05% azide. Also available WITHOUT BSA & azide at 1.0mg/ml. |
Storage condition : | Antibody with azide - store at 2 to 8°C. Antibody without azide - store at -20 to -80°C. Antibody is stable for 24 months. Non-hazardous. |
The insulin receptor (IR) is a heterodimeric protein complex that has an intracellular and an extracellular subunit, which is disulfide-linked to a transmembrane segment. The insulin ligand binds to the IR and initiates molecular signaling pathways that promote glucose uptake in cells and glycogen synthesis. Insulin binding to IR induces phosphorylation of intra-cellular tyrosine kinase domains and recruitment of multiple SH2 and SH3 domain-containing intracellular proteins that serve as signaling intermediates for pleiotropic effects of insulin. Type 1 diabetes is an auto-immune condition of the endocrine pancreas that results in destruction of insulin secreting cells and a progressive loss in insulin-sensitive glucose uptake by cells.
Immunohistochemistry (Formalin-fixed) (1-2µg/ml for 30 minutes at RT)(Staining of formalin-fixed tissues requires heating tissue sections in 10mM Tris with 1mM EDTA, pH 9.0, for 45 min at 95°C followed by cooling at RT for 20 minutes);
For Research Use Only. Not for use in diagnostic/therapeutics procedures.
Subcellular location: | Cell membrane |
Post transnational modification: | Autophosphorylated on tyrosine residues in response to insulin. Phosphorylation of Tyr-999 is required for binding to IRS1, SHC1 and STAT5B. Dephosphorylated by PTPRE at Tyr-999, Tyr-1185, Tyr-1189 and Tyr-1190. Dephosphorylated by PTPRF and PTPN1. Dephosphorylated by PTPN2; down-regulates insulin-induced signaling. |
Tissue Specificity: | Isoform Long and isoform Short are predominantly expressed in tissue targets of insulin metabolic effects: liver, adipose tissue and skeletal muscle but are also expressed in the peripheral nerve, kidney, pulmonary alveoli, pancreatic acini, placenta vascular endothelium, fibroblasts, monocytes, granulocytes, erythrocytes and skin. Isoform Short is preferentially expressed in fetal cells such as fetal fibroblasts, muscle, liver and kidney. Found as a hybrid receptor with IGF1R in muscle, heart, kidney, adipose tissue, skeletal muscle, hepatoma, fibroblasts, spleen and placenta (at protein level). Overexpressed in several tumors, including breast, colon, lung, ovary, and thyroid carcinomas. |
BioGrid: | 109854. 101 interactions. |
There are currently no product reviews
|